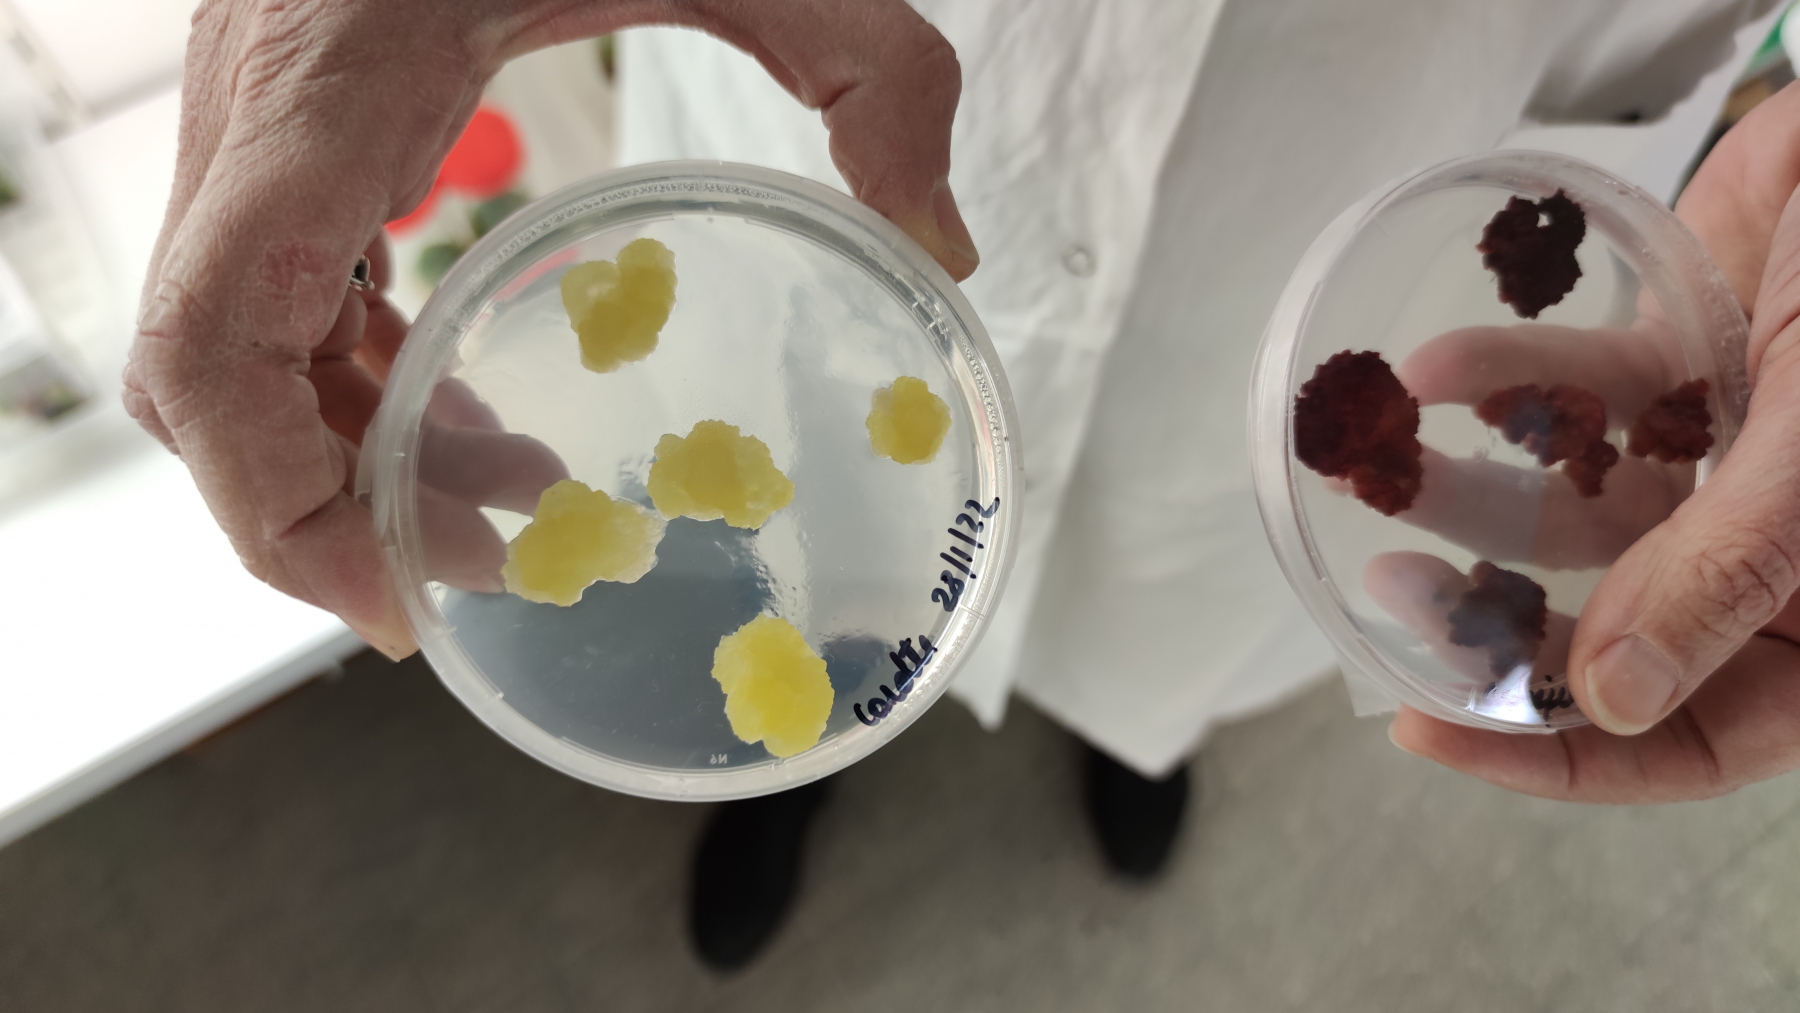

Formation sur les technologies des cultures végétales – Résumé

Cette formation a été menée par le Dr Caroline RAMBAUD, Maître de Conférences à l’Institut régional de recherche Charles Viollette (ICV), Cité scientifique de Lille. Mme Rambaud a accepté de partager le diaporama utilisé. Nous la remercions pour ces deux journées de formation.
Nos collègues Romain Mullier et Sébastien Dejean y ont assisté nous permettant d’avoir des photos d’illustration.
Le déroulement de ces 2 journées
1) Jour 1
Aspects Théoriques et Préparation des cultures
– « cours » sur les biotechnologies végétales et la culture in vitro.
– préparation des milieux de culture.
– aseptisation du matériel végétal.
– mises en culture d’explants de différentes espèces végétales : phase initiale (saintpaulia, pomme de terre, rosier ou ficus).
– culture de méristèmes (œillet).
– cultures de cals de carotte.
2) Jour 2
Analyse des cultures végétales
– évaluation des mises en culture du jour 1 et repiquage de ces cultures.
– préparation de protoplastes de chicorée.
– extraction d’ADN (oignon) et électrophorèse.
– cultures in vitro : phases de multiplication, développement et acclimatation (cactus, menthe, stévia, fougère, Dioneae et droséra).
– observation et comptage des protoplastes.
Aspects théoriques: partage du diaporama de Mme Rambaud
Diaporama mis à disposition pour consultation:
Quelques photos d’illustration
Quelques photos partagées par nos deux collègues afin d’illustrer le déroulement de ces deux journées:
Jour 1 (photos: Romain Mullier)